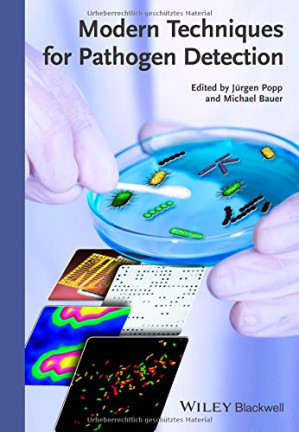
modern techniques for pathogen detection (2015 release)

Tropical Diseases: A Practical Guide for Medical Practitioners and Students
 Infectious Diseases A Clinical Short Course – 3rd Edition (In Thirty Days Series) – 2013 Edition
Infectious Diseases A Clinical Short Course – 3rd Edition (In Thirty Days Series) – 2013 Edition
Modern Techniques for Pathogen Detection (2015 Release)
Modern Techniques for Pathogen Detection (2015 Release)
Tropical Diseases: A Practical Guide for Medical Practitioners and Students
Original price was: $175.00.$4.99Current price is: $4.99.
-97%




